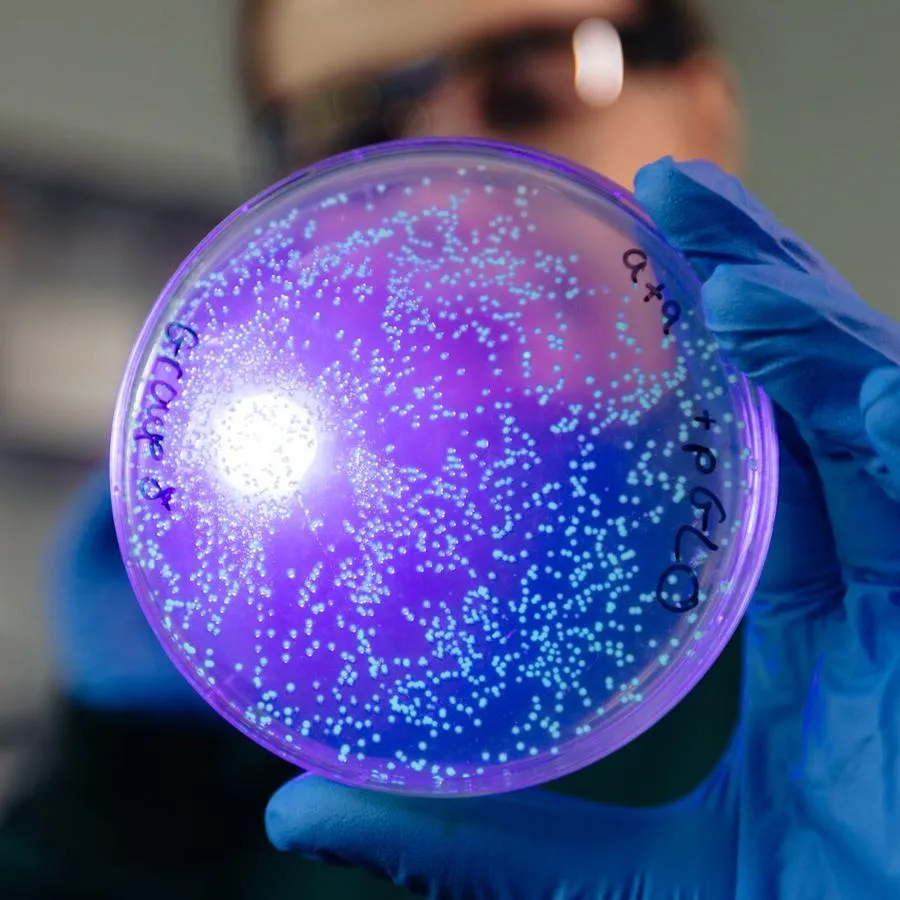
Biochemistry at the University of Hull

Biochemistry research degrees
The length of programme registration will be longer as it includes the maximum writing-up phase.
By choosing Biochemistry as a postgraduate at Hull, you will be joining a vibrant and forward-thinking research community. You can study at a variety of levels, right up to PhD.
£200K invested
in new teaching equipment
Strong links
with regional and global chemical companies
Work alongside
award-winning academics
Industry standard facilities
like our Turing and Super Labs
About our Biochemistry research degrees
You will join established research groups and find that we combine research expertise and cutting-edge facilities to deliver a unique experience. We pride ourselves on supporting our postgraduate students to make sure that you achieve your full potential. One of the University’s distinctive features is its strong research culture of collaboration and interdisciplinary working. The department and its researchers work together with, among others, biologists, clinicians, engineers (including chemical engineers), environmental scientists and, through the Hull York Medical School, with medics, on a variety of projects and initiatives.
We have some of the best-developed research links and industrial collaborations in the UK – including projects with local, regional, national and global chemical companies such as AstraZeneca, GlaxoSmithKline, Johnson-Matthey, Pfizer, Reckitt-Benckiser, Schlumberger and Unilever.
The department’s research is commercially exploited regarding patents, licensing and spin-out companies such as Chemtrix, Kingston Chemicals, Polar OLED and Sporomex. The Institute for Chemistry in Industry operates a long-established materials analysis consultancy focused on manufacturing industries in the Hull and Humber Region and their associated supply chains.
Research topics
Research
Our academic experts welcome postgraduate research applications across a broad range of topics. If you are interested in a research project with us, please have a look at the list below for guidance about the research areas in which the department can offer supervision.
Initial inquiries should be made to the member of staff whom you would like to supervise your research.
- Analytical sciences
- Medicinal and imaging chemistry
- Synthesis and catalysis
- Materials chemistry
The PGR Development Programme
The PGR Development Programme provides an excellent opportunity to build your academic and professional skills, supporting your success as a researcher and enhancing your future career prospects. It is designed to help you thrive in your research environment and prepare for the diverse challenges and opportunities that lie ahead.
Programme structure
Masters structure
| Full time | Part time |
|---|---|
| 1 year of research, with up to 12 months writing up if required | 2 years of research, with up to 24 months of writing up if required |
PhD structure
| Full time | Part time |
|---|---|
| 3 years of research, with up to 12 months writing up if required | 6 years of research, with up to 24 months of writing up if required |
Writing up and thesis submission
A standard full-time PhD programme comprised three years of research plus up to 12 months of thesis finalisation (also referred to as “writing-up”). Part-time is six years plus up to 24 months thesis finalisation if needed. Full-time standard Masters programmes are comprised one year of research plus up to 12 months of thesis finalisation needed; and part time Masters programmes have two years of research with up to two years of thesis finalisation.
For full-time students, the thesis finalisation phase should take three months but may be extended to one year without further paperwork. For part-time students, thesis finalisation should take six months, but may be extended to two years without further paperwork. The maximum thesis finalisation period is included in your overall programme length, which means that international PGRs will not need to apply for an additional visa to cover this phase.
If you need to move into the thesis finalisation period of your research degree, you must enrol for this phase and you will be liable to pay a continuation fee.
Thesis submission timelines
It is expected that you will submit your thesis within the timeframes outlined below:
Masters degrees
- Submission by one year and 3 months full-time.
- Submission by 2 years and 6 months part-time.
Doctoral degrees
- Submission by 3 years and 3 months full-time.
- Submission by 6 years and 6 months for part-time.
Entry Requirements
What do I need?
You should normally have, or expect to obtain, at least a 2:1 Honours degree, or international equivalent, in a related discipline appropriate to your intended research.
Contacting your prospective supervisor before you submit your application is not essential but may be helpful.
Typical offer
2:1 in a relevant subject area
Fees & Funding
How much is it?
Ready to get started?
Like what you’ve seen? Then it’s time to apply.
Make your application online now, and our admissions team will get back to you as soon as possible to make you an offer.
Got questions? We've got answers.
We’ve time for you anytime. Call or email our postgraduate admissions team today, and we'll be happy to help you.
International student? Please use the link below to get in touch with our international team for answers and advice.